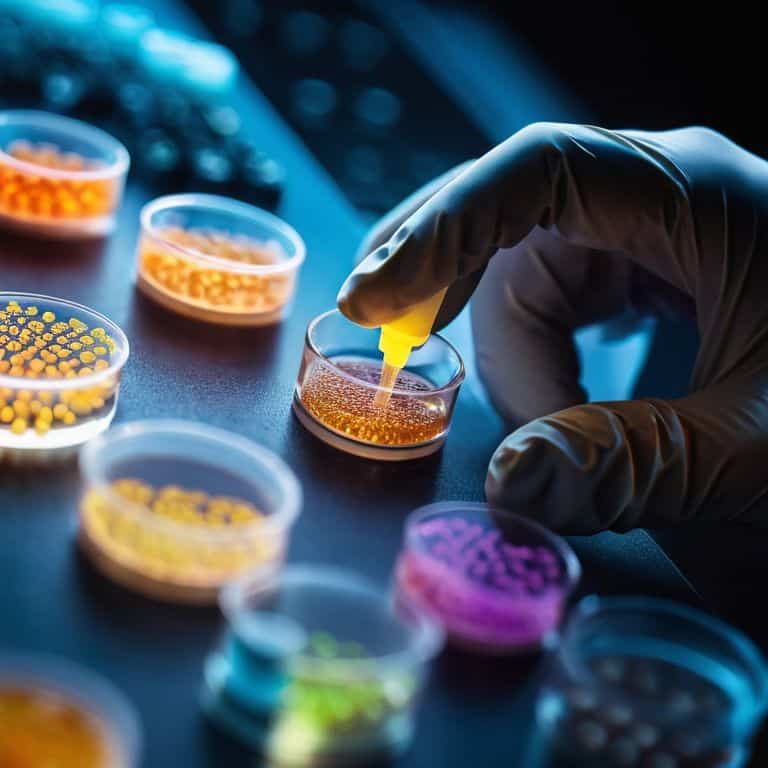
Unraveling the Mysteries of Gene Editing

I still remember the day I stumbled upon a gene editing article that claimed to reveal the secrets of how gene editing works. As an investigative journalist, I was appalled by the overly complicated language and the lack of concrete evidence. It was as if the authors were trying to confuse their readers rather than educate them. I’ve always believed that following the money trail is the key to understanding any complex topic, and gene editing is no exception. So, let’s get straight to the point – how gene editing works is not just a scientific concept, but a multi-billion dollar industry with far-reaching implications.
In this article, I promise to provide you with a no-nonsense guide to gene editing, free from hype and jargon. I’ll take you through the financial forces that shape this industry, and explain the science behind it in a clear and concise manner. My goal is to empower you with foundational knowledge, so you can make informed decisions about the role of gene editing in your life. I’ll draw from my experience as an investigative journalist to provide you with experience-based advice, and help you navigate the complex world of gene editing with confidence. By the end of this article, you’ll have a deep understanding of how gene editing works, and be able to separate fact from fiction.
Table of Contents
Gene Editing Explained

To truly understand the intricacies of gene editing, it’s essential to delve into the genome engineering techniques that make it possible. At its core, gene editing involves making precise changes to the DNA sequence of an organism. This is achieved through the use of advanced technologies, such as the CRISPR-Cas9 mechanism, which allows scientists to target and edit specific genes with unprecedented accuracy. By harnessing the power of these technologies, researchers can modify genes to correct inherited disorders, develop novel therapies, or even enhance certain traits.
The process of gene editing begins with DNA sequencing methods, which enable scientists to read the genetic code of an organism. This information is then used to identify the specific genes that need to be edited. Once the target genes have been identified, the CRISPR-Cas9 mechanism is used to make the necessary changes. This involves introducing a small piece of RNA that is complementary to the target gene, which guides the Cas9 enzyme to the correct location and allows it to make the desired edit. The resulting changes can have significant implications for gene therapy applications, enabling the development of new treatments for a wide range of diseases.
As gene editing technologies continue to evolve, they are likely to play an increasingly important role in the development of precision medicine approaches. By allowing scientists to tailor treatments to the specific needs of individual patients, gene editing has the potential to revolutionize the field of medicine. However, the use of gene editing also raises important questions about genetic modification ethics, highlighting the need for careful consideration and regulation of these powerful technologies.
Crispr Cas9 Mechanism Uncovered
As I delve into the world of gene editing, I find myself fascinated by the CRISPR Cas9 mechanism. This complex process involves a series of precise steps, where the Cas9 enzyme acts as a molecular scissors, cutting the DNA at a specific location. The CRISPR system then uses a small RNA molecule to guide the Cas9 enzyme to the target site, allowing for precise editing of the genetic code.
The precision editing capabilities of CRISPR Cas9 have revolutionized the field of gene editing, enabling scientists to make targeted changes to the genome with unprecedented accuracy. By understanding the intricacies of this mechanism, researchers can harness its power to develop innovative therapies and treatments, opening up new avenues for medical breakthroughs.
Dna Sequencing Methods Decoded
To truly understand gene editing, it’s essential to grasp the concept of DNA sequencing, which is the process of determining the order of the four chemical building blocks, or nucleotides, that make up an organism’s DNA. Sequencing methods have evolved significantly over the years, from the early days of Sanger sequencing to the more modern and efficient next-generation sequencing (NGS) technologies.
The cost per genome has decreased dramatically with advancements in NGS, making it possible to sequence entire genomes quickly and affordably. This, in turn, has enabled researchers to identify specific genetic variations associated with diseases, paving the way for targeted gene editing therapies.
How Gene Editing Works

As I delve into the world of genome engineering techniques, I’m reminded that gene editing is a multifaceted field that requires a deep understanding of the underlying biology. The CRISPR Cas9 mechanism, in particular, has revolutionized the way we approach genetic modification, allowing for unprecedented precision and efficiency. By harnessing the power of this technology, scientists can now make targeted changes to the genome, opening up new avenues for gene therapy applications.
The process of gene editing involves several key steps, including DNA sequencing methods to identify the target gene, and the use of enzymes to cut and edit the DNA. This is followed by the integration of new genetic material, which can be used to introduce new traits or correct existing genetic errors. As we explore the possibilities of gene editing, it’s essential to consider the genetic modification ethics that surround this technology, ensuring that we use these powerful tools responsibly and with caution.
As we move forward in this field, it’s clear that gene editing will play a critical role in the development of precision medicine approaches, enabling us to tailor treatments to individual patients and their unique genetic profiles. By continuing to advance our understanding of genome engineering techniques, we can unlock new possibilities for human health and wellbeing, and create a brighter future for generations to come.
Gene Therapy Applications Explored
As I delve into the world of gene editing, I’m struck by the vast potential of gene therapy in treating genetic disorders. This innovative approach has already shown promising results in clinical trials, offering new hope for patients with previously incurable diseases. By targeting the root cause of genetic mutations, gene therapy aims to restore normal cellular function, thereby alleviating symptoms and improving quality of life.
The economic implications of gene therapy are also worth exploring, as private investment pours into this burgeoning field. With several biotech companies racing to develop gene therapies, the market is expected to grow significantly in the coming years, driven by the demand for effective treatments and the potential for substantial returns on investment.
Genome Engineering Techniques Revealed
As we delve deeper into the world of gene editing, it’s essential to understand the various genome engineering techniques that scientists employ. These techniques allow researchers to manipulate the genetic code with unprecedented precision, enabling them to modify genes in a targeted and efficient manner. By leveraging these techniques, scientists can introduce specific changes to the genome, which can have significant implications for fields such as medicine and biotechnology.
One of the key challenges in genome engineering is ensuring that the desired changes are introduced accurately and reliably. To address this challenge, researchers often rely on advanced computational tools, which enable them to simulate gene editing outcomes and predict the potential effects of different genetic modifications. This allows scientists to refine their approaches and optimize their techniques for maximum efficacy.
Unraveling the Mysteries of Gene Editing: 5 Essential Insights
- Understand the CRISPR Cas9 mechanism as the cornerstone of modern gene editing, allowing for precise modifications to the genome
- Recognize the role of DNA sequencing methods in identifying and verifying the genetic changes made through gene editing, ensuring accuracy and efficacy
- Explore the various genome engineering techniques, including homologous recombination and base editing, to grasp the full scope of gene editing capabilities
- Delve into the applications of gene therapy, from treating genetic disorders to enhancing human traits, to appreciate the potential impact of gene editing on human health and society
- Follow the financial trail to comprehend how investments and funding shape the development and accessibility of gene editing technologies, influencing their integration into medical and research practices
Key Takeaways: Unpacking the Complexities of Gene Editing
Gene editing, particularly through the CRISPR Cas9 mechanism, offers unprecedented precision in modifying genes, with potential applications ranging from treating genetic diseases to enhancing human traits, all of which are driven by significant financial investments from both private and public sectors
Understanding the DNA sequencing methods and genome engineering techniques is crucial for grasping how gene editing works, including the processes of gene therapy which hold promise for curing previously incurable diseases, but also come with ethical and economic considerations that must be carefully navigated
Ultimately, the future of gene editing will be shaped not only by scientific breakthroughs, but also by the economic forces and regulatory frameworks that influence research funding, accessibility, and the ethical use of these technologies, making it essential to follow the money trail to comprehend the full implications of gene editing on society
Unraveling the Mysteries of Gene Editing
Gene editing is not just a scientific marvel, but a multibillion-dollar industry where the stakes are high, the players are powerful, and the outcomes will shape the future of humanity – and if we’re to truly understand its potential, we must first follow the money trail to uncover the economic forces driving this revolution.
Cora Maxwell
Unraveling the Mysteries of Gene Editing
As we conclude our journey into the world of gene editing, it’s clear that understanding the CRISPR Cas9 mechanism and DNA sequencing methods is crucial for grasping the full potential of this technology. By delving into the intricacies of genome engineering techniques and exploring the applications of gene therapy, we’ve gained a deeper appreciation for the complex interplay between science, technology, and the human experience. The financial forces driving gene editing’s development have also become apparent, with investments in research and development paving the way for innovative treatments and therapies.
As we look to the future, it’s essential to recognize that gene editing is not just a scientific tool, but a catalyst for change. By following the money trail and uncovering the economic forces behind this technology, we can ensure that its benefits are equitably distributed and that its risks are carefully managed. As we continue to push the boundaries of human knowledge, we must remain vigilant, asking tough questions and seeking answers that will ultimately shape the course of human history.
Frequently Asked Questions
What are the potential risks and unintended consequences of using CRISPR Cas9 for gene editing?
As I dug into the financial forces behind CRISPR Cas9, I found that the rush to market has raised concerns about mosaicism, germline editing, and unforeseen off-target effects – all of which demand rigorous scrutiny and transparent regulation to mitigate the risks of this powerful technology.
How do scientists ensure the accuracy and specificity of gene editing when using DNA sequencing methods?
To ensure accuracy and specificity, scientists employ rigorous quality control measures, such as validating DNA sequencing data through multiple rounds of sequencing and using sophisticated bioinformatics tools to analyze and verify the results, all while carefully tracking the financial investments that drive these precise technologies.
Can gene therapy be used to treat complex diseases, and what are the current limitations and future prospects of this technology?
Gene therapy holds promise for treating complex diseases, but its effectiveness is hindered by delivery challenges and off-target effects. Current limitations include scalability and cost, but advances in vector design and gene editing technologies like CRISPR are paving the way for future breakthroughs, with many clinical trials underway to tackle devastating conditions like sickle cell anemia and muscular dystrophy.




